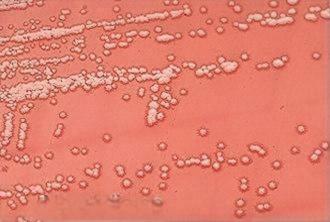
Нокардия

Просмотры:4 Автор:Pедактор сайта Время публикации: 2024-08-15 Происхождение:Работает








ПЭТ, сокращение от полиэтилентерефталата., представляет собой тип термопластичного полимера. Вы также можете услышать, что его называют PETE, а в прошлом он был известен как PETP или PET-P. Термопластичность ПЭТ означает, что его можно нагревать, плавить, а затем охлаждать, придавая ему различные формы, что делает его особенно популярным в упаковочной промышленности, как для мягкой, так и для жесткой упаковки. Кроме того, ПЭТ — прочный, инертный материал, который не вступает в реакцию с пищевыми продуктами, что является важной причиной того, что он широко используется для упаковки пищевых продуктов и бутылок для напитков. Кроме того, он экономически эффективен, что еще больше повышает его популярность.


ПЭТ занимает четвертое место по объему производства полимеров после ПЭ (полиэтилена), ПП (полипропилена) и ПВХ (поливинилхлорида). К 2016 году ПЭТ уже использовался более чем в 60% производств волокна, а на ПЭТ-бутылки приходилось около трети мирового спроса, что делало его основным продуктом как в текстильной, так и в упаковочной промышленности.

ДОМАШНИЙ ПИТОМЕЦ

ЧП

ПП

ПВХ
ПЭТ состоит из повторяющихся звеньев C10H8O4. В большинстве случаев ПЭТ производится из ПТА, хотя некоторые из них изготавливаются из МЭГ и ДМТ. По состоянию на 2022 год этиленгликоль в ПЭТ по-прежнему получают из этилена, природного газа, а терефталевая кислота — из пара-ксилола, который получают из сырой нефти. При производстве ПЭТ в качестве катализатора используются сурьма или титан, стабилизаторами служат фосфиты, а для маскировки пожелтения добавляются соли кобальта и воронители.


Медленная скорость кристаллизации ПЭТ облегчает его растяжение в процессе производства, поэтому он идеально подходит для изготовления волокон и пленок.

полиэфирное волокно

полиэфирное волокно
Будучи ароматическим полимером, ПЭТ обладает лучшими барьерными свойствами, чем алифатические полимеры, а также является гидрофобным.


Коммерческие продукты из ПЭТ обычно имеют кристалличность до 60%. Быстро охлаждая расплавленный полимер до температуры стеклования, можно производить прозрачные продукты. Более медленное охлаждение приводит к получению полупрозрачных продуктов. Ориентация во время производства также может повысить прозрачность, что объясняет, почему пленки и бутылки из БОПЭТ одновременно прозрачны и кристалличны.


ПЭТ широко используется для изготовления пластиковых бутылок для безалкогольных напитков, включая как газированные, так и негазированные напитки. Для напитков, которые легко разлагаются, таких как пиво, ПЭТ часто наслаивается другими материалами, чтобы уменьшить проницаемость кислорода.




В гибкой упаковке ПЭТ обычно ориентирован биаксиально. БОПЭТ пленка, материал, который вам, возможно, лучше известен по торговому названию Майлар. После ориентации дополнительная обработка, такая как металлизация, может еще больше снизить проницаемость, делая пленку отражающей и непрозрачной, поэтому она так широко используется в упаковке пищевых продуктов и изоляционных материалах.




ПЭТ широко используется в текстильной промышленности благодаря своей превосходной пластичности, как упоминалось ранее. Эти полиэфирные волокна обычно встречаются в модной одежде, часто смешиваются с хлопком и используются для термобелья, спортивной одежды, спецодежды и автомобильной обивки.


Хотя большинство термопластов поддаются вторичной переработке, ПЭТ особенно легко поддается вторичной переработке. Частично это связано с его высокой стоимостью и тем фактом, что ПЭТ обычно используется для изготовления бутылок с водой, что делает его популярным выбором для переработки. В отличие от других пластиков, таких как ПВХ (используется для пищевой пленки), ПП (контейнеры для пищевых продуктов) и ПС (одноразовые стаканчики), ПЭТ можно многократно перерабатывать в одни и те же продукты, что значительно сокращает количество отходов. Во многих странах для обозначения этого используется универсальный символ переработки с идентификационным кодом смолы (RIC) 1 (♳) на нижней стороне изделий из ПЭТ.
Более того, производство ПЭТ потребляет меньше энергии и генерирует меньше выбросов углекислого газа по сравнению с другими материалами. Меньший вес изделий из ПЭТ также означает меньшие выбросы углекислого газа во время транспортировки.

ПВХ пленка

ПП Коробка

Одноразовые палочки для еды PS PP

Знак переработки ПЭТ
Переработанный ПЭТ часто называют RPET или R-PET, также широко используется переработанный ПЭТ (POSTC PET). Помимо переработки в ту же продукцию, ПЭТ можно перерабатывать в обвязочные ленты и контейнеры для непищевых продуктов. В 2023 году был внедрен новый процесс производства суперконденсаторов из ПЭТФ, превращающий его в углеродсодержащие листы и наносферы. Кроме того, ПЭТ является идеальным топливом для энергетических предприятий из-за его высокого содержания тепла, что помогает снизить зависимость от невозобновляемых ресурсов.

Тип ПЭТ

ПЭТ-контейнер
Если ПЭТ не перерабатывается вручную, а выбрасывается, не о чем беспокоиться. Некоторые бактерии рода Nocardia могут разлагать ПЭТ с помощью ферментов липазы. Эти бактерии широко распространены в почве, поэтому ПЭТ может расщепляться естественным путем.
Нокардия

Нокардия
Прежде чем обсуждать потенциальные проблемы с ПЭТ, важно упомянуть сурьму. Этот металлоидный элемент обычно используется в качестве катализатора при производстве ПЭТ. После изготовления изделий из ПЭТ на поверхности изделия можно обнаружить остаточную сурьму. Со временем эти элементы сурьмы могут мигрировать в содержимое, например, в еду и напитки. Воздействие микроволн на ПЭТ может значительно повысить уровень сурьмы, потенциально превышая максимальный стандарт EPA. Хотя риски для здоровья минимальны, это все равно вызывает беспокойство.

Сурьма

Сурьма
Поскольку ПЭТ широко используется в текстильной промышленности, многие предметы одежды могут терять волокна во время использования и стирки. Некоторые из этих волокон распадаются на мелкие частицы, которые могут оседать в реках или океанах и попадать в организм рыб, попадая в пищевую цепь. Другие волокна могут перемещаться по воздуху и в конечном итоге потребляться домашним скотом и растениями, в конечном итоге попадая в наши запасы пищи.
ПЭТ — экологически чистый материал, который легче перерабатывать и имеет более высокую ценность при переработке по сравнению с аналогами. Хотя у него могут быть некоторые потенциальные проблемы с безопасностью, они минимальны по сравнению с его преимуществами. Поскольку все больше стран принимают меры против загрязнения пластиком, ПЭТ предлагает жизнеспособное решение для многих отраслей.